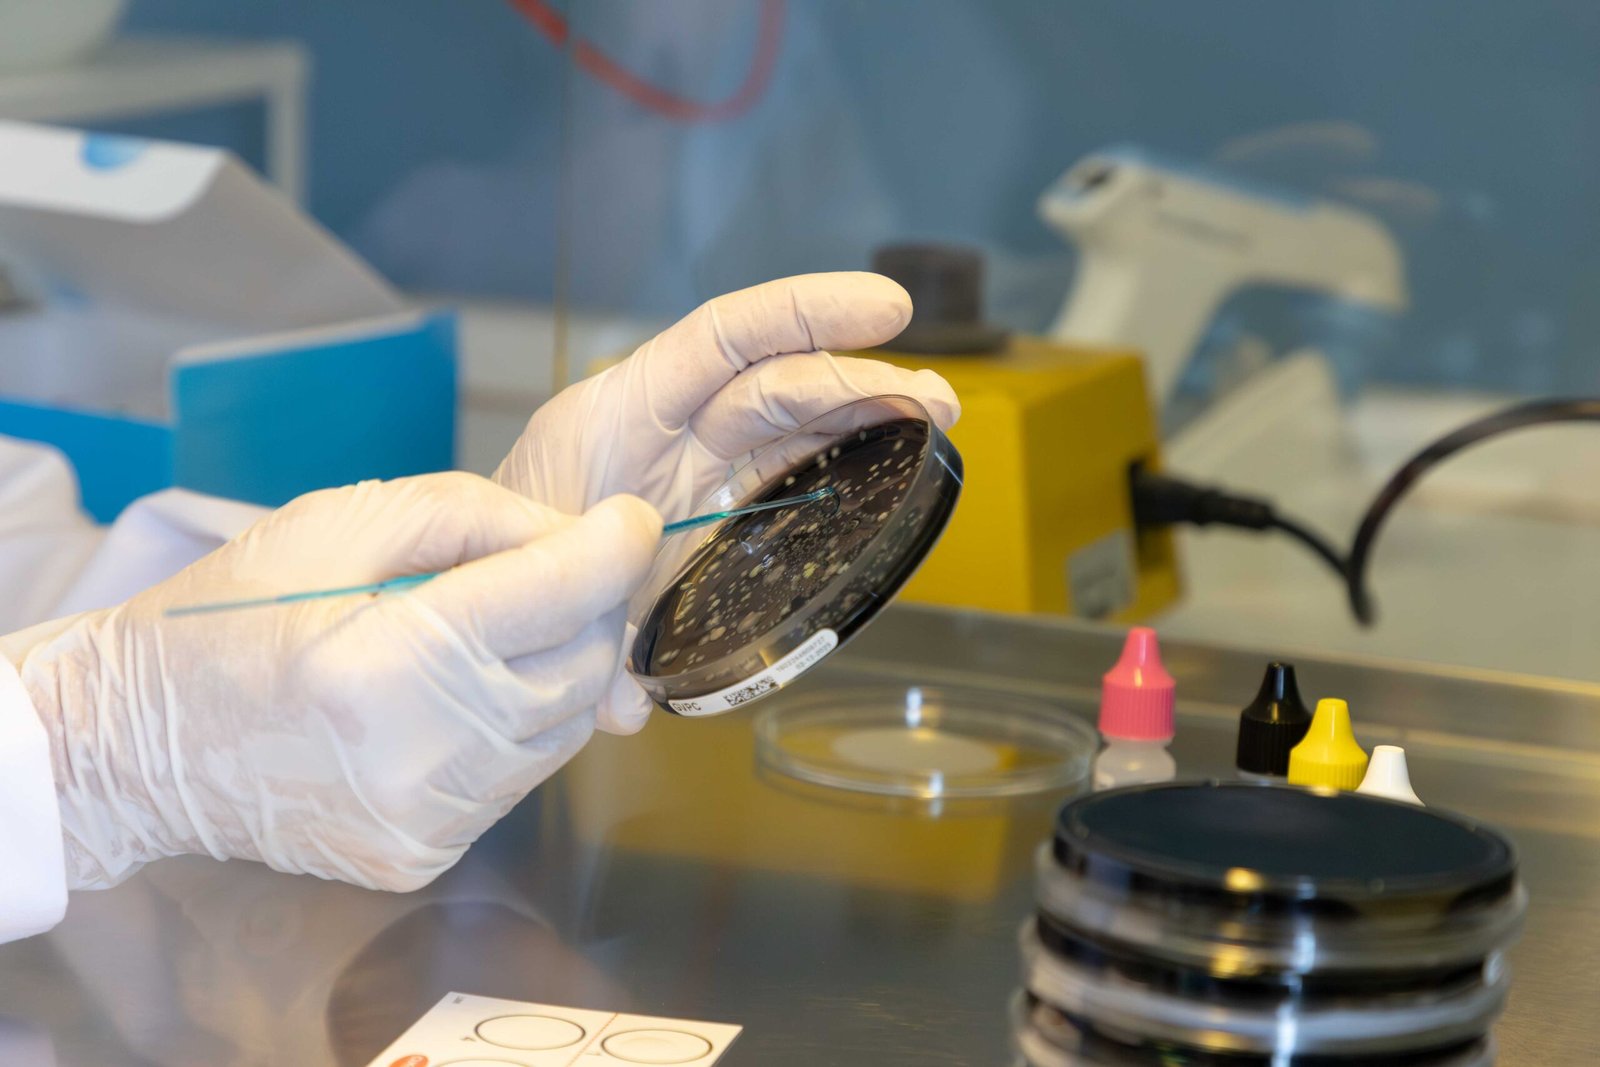
Agronomic and soil analysis at L.A.C. accredited laboratory

Certified Analytical Solutions for Environment and Industry
Accredited laboratory in Cremona for environmental analysis throughout Northern Italy.
Ensuring quality excellence through certified testing
LAC carries out accredited chemical and microbiological analyses to support environmental protection, industrial process monitoring and product safety. With advanced technologies and certified methods, the laboratory ensures accurate, reliable and fully traceable data. We support companies and professionals with technical expertise, regulatory compliance-oriented tests and constant support at every stage of the analytical process.
Scientific Accuracy as an operational standard
Equipped with advanced instrumentation and accredited ISO/IEC 17025, LAC guarantees high quality standards at every stage of the analytical process. We provide reliable, traceable and compliant data, to support the technical decisions of companies, institutions and professionals.
By the Numbers
More than 35 years of scientific experience, with constantly growing data and volumes and confirm the trust that many renew in us every year.